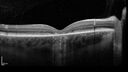
stargardts_2020_105079_05.jpg

|
|

Achromatopsia79 views28 year old female Good vision since birth started wearing glasses at 2, denies trauma. She does have congenital nystagmus.
VA OD: Dcc20/200-2 PH20/200 NccJ7
VA OS: Dcc20/160 PHNI NccJ7
IOP: TP: OD:15 OS:12
|
|

Chronic Myelogenous Leukemia and Diabetic Macular Edema79 views71 year old female with 3 months of vision loss and not feeling well. She has been bruising on her legs. Her vision was 20/100 in each eye with macular edema. She was treated with Avastin and her CBC was checked. She had a WBC of 267 thousand and was diagnosed with CML.
|
|

Chronic Myelogenous Leukemia and Diabetic Macular Edema79 views71 year old female with 3 months of vision loss and not feeling well. She has been bruising on her legs. Her vision was 20/100 in each eye with macular edema. She was treated with Avastin and her CBC was checked. She had a WBC of 267 thousand and was diagnosed with CML.
|
|

Chronic Myelogenous Leukemia and Diabetic Macular Edema79 views71 year old female with 3 months of vision loss and not feeling well. She has been bruising on her legs. Her vision was 20/100 in each eye with macular edema. She was treated with Avastin and her CBC was checked. She had a WBC of 267 thousand and was diagnosed with CML.
|
|

Retinal Arterial Macroaneurysm with pre-retinal hemorrhage79 views72 year old female who takes Xarelto had sudden vision loss while moving heavy furniture. VA was 20/200. The lesion has preretinal blood but later rebled with subretinal blood, was lasered and the final vision was not very good but the patient was lost to follow-up at 3 months
|
|

wet AMD with classic extrafoveal macular neovascularization in the good eye79 views89 year old man with longstanding vision loss in the left eye presented with one month of mild vision loss in the right eye. Vision was 20/32. This eye responded to vabysmo therapy.
|
|

wet AMD with classic extrafoveal macular neovascularization in the good eye79 views89 year old man with longstanding vision loss in the left eye presented with one month of mild vision loss in the right eye. Vision was 20/32. This eye responded to vabysmo therapy.
|
|

Fresh BRAO in patient with wet AMD79 views91 year old female She noticed last night a shadow over the left eye. When she closes her right eye she cannot see the bottom of the vision in the left eye. This is new.
VA OD: sc20/32-1
VA OS: sc20/32-2
|
|

Choroidal Melanocystosis79 views65 year old female with normal vision.
|
|

Wet AMD - Type 1 CNVM - RAP lesion79 views92 year old man with vision loss and very high PED. Because of worry about a PED tear, patient was treated with avastin, then lucentis, then eyelea, then vabysmo (progressively stronger meds)
|
|

Wet AMD - Type 1 CNVM - RAP lesion79 views92 year old man with vision loss and very high PED. Because of worry about a PED tear, patient was treated with avastin, then lucentis, then eyelea, then vabysmo (progressively stronger meds)
|
|

32 year old with peripheral CHRPE79 views
|
|

32 year old with peripheral CHRPE79 views
|
|

Myelinated Nerve Fiber Layer - Peripheral79 views43 year old man with floaters
|
|

Myopic CNVM Left Eye79 views80 year old female. VA dropped to 20/125 but improved back up to 20/50 with Vabysmo
|
|

Albinism and Renal failure - Possible Hermansky-Pudlak Syndrome79 views65 year old female with foveal hypoplasia and renal failure since age 18. VA 20/40 OD, 20/63 OS
|
|

West Nile Virus Multifocal Choroiditis with later CNVM79 views77 year old female with vision loss in the left eye treated with Anti-VEGF
|
|

West Nile Virus Multifocal Choroiditis with later CNVM79 views77 year old female with vision loss in the left eye treated with Anti-VEGF
|
|

West Nile Virus Multifocal Choroiditis with later CNVM79 views77 year old female with vision loss in the left eye treated with Anti-VEGF
|
|

West Nile Virus Multifocal Choroiditis with later CNVM79 views77 year old female with vision loss in the left eye treated with Anti-VEGF
|
|

Idiopathic Polypoidal Choroidal Vasculopathy79 views83 year old man with wet AMD for 12 years resistant to Anti-VEGF therapy but responsive to PDT
|
|

Chronic Myelogenous Leukemia and Diabetic Macular Edema78 views71 year old female with 3 months of vision loss and not feeling well. She has been bruising on her legs. Her vision was 20/100 in each eye with macular edema. She was treated with Avastin and her CBC was checked. She had a WBC of 267 thousand and was diagnosed with CML.
|
|

Retinal Arterial Macroaneurysm with pre-retinal hemorrhage78 views72 year old female who takes Xarelto had sudden vision loss while moving heavy furniture. VA was 20/200. The lesion has preretinal blood but later rebled with subretinal blood, was lasered and the final vision was not very good but the patient was lost to follow-up at 3 months
|
|

wet AMD with classic extrafoveal macular neovascularization in the good eye78 views89 year old man with longstanding vision loss in the left eye presented with one month of mild vision loss in the right eye. Vision was 20/32. This eye responded to vabysmo therapy.
|
|

32 year old female with normal vision and CHRPE78 views
|
|

32 year old female with normal vision and CHRPE78 views
|
|

Wet AMD - Occult CNVM and Geographic atrophy78 views77 year old female with mild vision loss - 20/32 - responded to Avastin
|
|

Ruptured Retinal Arterial Macroaneurysm - Submacular hemorrhage and BRAO78 views81 year old female with vision loss for a few days. Coumadin was high with INR at 3.1 VA 6/200
|
|

Ruptured Retinal Arterial Macroaneurysm - Submacular hemorrhage and BRAO78 views81 year old female with vision loss for a few days. Coumadin was high with INR at 3.1 VA 6/200
|
|

Ruptured Retinal Arterial Macroaneurysm - Submacular hemorrhage and BRAO78 views81 year old female with vision loss for a few days. Coumadin was high with INR at 3.1 VA 6/200
|
|

Prethreshold PDR right eye - mild NVD78 views
|
|

West Nile Virus Multifocal Choroiditis with later CNVM78 views77 year old female with vision loss in the left eye treated with Anti-VEGF
|
|

West Nile Virus Multifocal Choroiditis with later CNVM78 views77 year old female with vision loss in the left eye treated with Anti-VEGF
|
|

Macular fold - resolved with time78 views
|
|

BRAO - plaques in vessels - GIF video of FA78 views78 year old female with vision loss for 1 week and old macular scar. Images show BRAO with plaques and FA shows occlusion.
|
|

BRAO - plaques in vessels - GIF video of FA78 views78 year old female with vision loss for 1 week and old macular scar. Images show BRAO with plaques and FA shows occlusion.
|
|

Paracentral acute middle maculopathy - isolated77 views83 year old man New spot in the vision yesterday left eye.
Medical Hx: Pure Hypercholesterolemia
Systemic Meds: Crestor.
VA OD: Dcc20/20
VA OS: Dcc20/20
IOP: TP: OD:19 OS:10
|
|

Chronic Myelogenous Leukemia and Diabetic Macular Edema77 views71 year old female with 3 months of vision loss and not feeling well. She has been bruising on her legs. Her vision was 20/100 in each eye with macular edema. She was treated with Avastin and her CBC was checked. She had a WBC of 267 thousand and was diagnosed with CML.
|
|

Retinal Arterial Macroaneurysm with pre-retinal hemorrhage77 views72 year old female who takes Xarelto had sudden vision loss while moving heavy furniture. VA was 20/200. The lesion has preretinal blood but later rebled with subretinal blood, was lasered and the final vision was not very good but the patient was lost to follow-up at 3 months
|
|

wet AMD with classic extrafoveal macular neovascularization in the good eye77 views89 year old man with longstanding vision loss in the left eye presented with one month of mild vision loss in the right eye. Vision was 20/32. This eye responded to vabysmo therapy.
|
|

wet AMD with classic extrafoveal macular neovascularization in the good eye77 views89 year old man with longstanding vision loss in the left eye presented with one month of mild vision loss in the right eye. Vision was 20/32. This eye responded to vabysmo therapy.
|
|

Fresh BRAO in patient with wet AMD77 views91 year old female She noticed last night a shadow over the left eye. When she closes her right eye she cannot see the bottom of the vision in the left eye. This is new.
VA OD: sc20/32-1
VA OS: sc20/32-2
|
|

Central Retinal Vein Occlusion with cilioretinal artery occlusion77 views63 year old female who lost vision in the left eye 2 days ago. She was in the emergency room and had a lot of tests done which were all reportedly normal. The right eye is OK.
VA OD: Dcc20/25 NccJ2
VA OS: Dcc20/200-1 PHNI Ncc20/400-1
IOP: TP: OD:11 OS:12
|
|

Wet AMD - Type 1 CNVM - RAP lesion77 views92 year old man with vision loss and very high PED. Because of worry about a PED tear, patient was treated with avastin, then lucentis, then eyelea, then vabysmo (progressively stronger meds)
|
|

Wet AMD - Type 1 CNVM - RAP lesion77 views92 year old man with vision loss and very high PED. Because of worry about a PED tear, patient was treated with avastin, then lucentis, then eyelea, then vabysmo (progressively stronger meds)
|
|

Stargardt - Mother with Stargadts and father with RP77 viewsHer mom is genetically visually impaired with Stargardts. Her father has RP. The mother was genetically tested in Boston about 23 years ago. That was when the gene was first being isolated. (The mother has seven brothers and sisters and four have stargardts and they are legally blind. Also one cousin has it.)
VA OD: 20/160 OS: 20/160
She tested positive for ABCA4
|
|

Myelinated Nerve Fiber Layer - Peripheral77 views43 year old man with floaters
|
|

Ruptured Retinal Arterial Macroaneurysm - Submacular hemorrhage and BRAO77 views81 year old female with vision loss for a few days. Coumadin was high with INR at 3.1 VA 6/200
|
|

Ruptured Retinal Arterial Macroaneurysm - Submacular hemorrhage and BRAO77 views81 year old female with vision loss for a few days. Coumadin was high with INR at 3.1 VA 6/200
|
|

Ruptured Retinal Arterial Macroaneurysm - Submacular hemorrhage and BRAO77 views81 year old female with vision loss for a few days. Coumadin was high with INR at 3.1 VA 6/200
|
|

Ruptured Retinal Arterial Macroaneurysm - Submacular hemorrhage and BRAO77 views81 year old female with vision loss for a few days. Coumadin was high with INR at 3.1 VA 6/200
|
|

Prethreshold PDR right eye - mild NVD77 views
|
|

West Nile Virus Multifocal Choroiditis with later CNVM77 views77 year old female with vision loss in the left eye treated with Anti-VEGF
|
|

West Nile Virus Multifocal Choroiditis with later CNVM77 views77 year old female with vision loss in the left eye treated with Anti-VEGF
|
|

West Nile Virus Multifocal Choroiditis with later CNVM77 views77 year old female with vision loss in the left eye treated with Anti-VEGF
|
|

Macular fold - resolved with time77 views
|
|

NPDR and Severe macular ischemia sudden vision loss77 views60 year old female with sudden vision loss OD 1 week ago. VA 20/63, 20/200. OCT-A and FA shows severe macular ischemia OU
|
|

Chronic Myelogenous Leukemia and Diabetic Macular Edema76 views71 year old female with 3 months of vision loss and not feeling well. She has been bruising on her legs. Her vision was 20/100 in each eye with macular edema. She was treated with Avastin and her CBC was checked. She had a WBC of 267 thousand and was diagnosed with CML.
|
|

Fresh BRAO in patient with wet AMD76 views91 year old female She noticed last night a shadow over the left eye. When she closes her right eye she cannot see the bottom of the vision in the left eye. This is new.
VA OD: sc20/32-1
VA OS: sc20/32-2
|
|

Wet AMD - Type 1 CNVM - RAP lesion76 views92 year old man with vision loss and very high PED. Because of worry about a PED tear, patient was treated with avastin, then lucentis, then eyelea, then vabysmo (progressively stronger meds)
|
|
Stargardt - Mother with Stargadts and father with RP76 viewsHer mom is genetically visually impaired with Stargardts. Her father has RP. The mother was genetically tested in Boston about 23 years ago. That was when the gene was first being isolated. (The mother has seven brothers and sisters and four have stargardts and they are legally blind. Also one cousin has it.)
VA OD: 20/160 OS: 20/160
She tested positive for ABCA4
|
|

Myelinated Nerve Fiber Layer - Peripheral76 views43 year old man with floaters
|
|

Ruptured Retinal Arterial Macroaneurysm - Submacular hemorrhage and BRAO76 views81 year old female with vision loss for a few days. Coumadin was high with INR at 3.1 VA 6/200
|
|

Prethreshold PDR right eye - mild NVD76 views
|
|

West Nile Virus Multifocal Choroiditis with later CNVM76 views77 year old female with vision loss in the left eye treated with Anti-VEGF
|
|

West Nile Virus Multifocal Choroiditis with later CNVM76 views77 year old female with vision loss in the left eye treated with Anti-VEGF
|
|

West Nile Virus Multifocal Choroiditis with later CNVM76 views77 year old female with vision loss in the left eye treated with Anti-VEGF
|
|

Birdshot Chorioretinitis - Chronic Untreated with Drusen Like Material in Macula76 views72 year old female with vision changes for years just now diagnosed with Birdshot.
|
|

Birdshot Chorioretinitis - Chronic Untreated with Drusen Like Material in Macula76 views72 year old female with vision changes for years just now diagnosed with Birdshot.
|
|

Macular fold - resolved with time76 views
|
|

Paracentral acute middle maculopathy - isolated75 views83 year old man New spot in the vision yesterday left eye.
Medical Hx: Pure Hypercholesterolemia
Systemic Meds: Crestor.
VA OD: Dcc20/20
VA OS: Dcc20/20
IOP: TP: OD:19 OS:10
|
|

Chronic Myelogenous Leukemia and Diabetic Macular Edema75 views71 year old female with 3 months of vision loss and not feeling well. She has been bruising on her legs. Her vision was 20/100 in each eye with macular edema. She was treated with Avastin and her CBC was checked. She had a WBC of 267 thousand and was diagnosed with CML.
|
|

Chronic Myelogenous Leukemia and Diabetic Macular Edema75 views71 year old female with 3 months of vision loss and not feeling well. She has been bruising on her legs. Her vision was 20/100 in each eye with macular edema. She was treated with Avastin and her CBC was checked. She had a WBC of 267 thousand and was diagnosed with CML.
|
|

Retinal Arterial Macroaneurysm with pre-retinal hemorrhage75 views72 year old female who takes Xarelto had sudden vision loss while moving heavy furniture. VA was 20/200. The lesion has preretinal blood but later rebled with subretinal blood, was lasered and the final vision was not very good but the patient was lost to follow-up at 3 months
|
|

Wet AMD - Type 1 CNVM - RAP lesion75 views92 year old man with vision loss and very high PED. Because of worry about a PED tear, patient was treated with avastin, then lucentis, then eyelea, then vabysmo (progressively stronger meds)
|
|

Wet AMD - Type 1 CNVM - RAP lesion75 views92 year old man with vision loss and very high PED. Because of worry about a PED tear, patient was treated with avastin, then lucentis, then eyelea, then vabysmo (progressively stronger meds)
|
|

Wet AMD - Type 1 CNVM - RAP lesion75 views92 year old man with vision loss and very high PED. Because of worry about a PED tear, patient was treated with avastin, then lucentis, then eyelea, then vabysmo (progressively stronger meds)
|
|

Wet AMD - Type 1 CNVM - RAP lesion75 views92 year old man with vision loss and very high PED. Because of worry about a PED tear, patient was treated with avastin, then lucentis, then eyelea, then vabysmo (progressively stronger meds)
|
|

Wet AMD - Occult CNVM and Geographic atrophy75 views77 year old female with mild vision loss - 20/32 - responded to Avastin
|
|

Ruptured Retinal Arterial Macroaneurysm - Submacular hemorrhage and BRAO75 views81 year old female with vision loss for a few days. Coumadin was high with INR at 3.1 VA 6/200
|
|

Albinism and Renal failure - Possible Hermansky-Pudlak Syndrome75 views65 year old female with foveal hypoplasia and renal failure since age 18. VA 20/40 OD, 20/63 OS
|
|

Prethreshold PDR right eye - mild NVD75 views
|
|

Severe NPDR with non-perfusion on FA75 views64 year old man with 20/32 vision in both eyes and mild blurring. FA shows non-perfusion but no proliferation
|
|

NPDR and Severe macular ischemia sudden vision loss75 views60 year old female with sudden vision loss OD 1 week ago. VA 20/63, 20/200. OCT-A and FA shows severe macular ischemia OU
|
|

Paracentral acute middle maculopathy - isolated74 views83 year old man New spot in the vision yesterday left eye.
Medical Hx: Pure Hypercholesterolemia
Systemic Meds: Crestor.
VA OD: Dcc20/20
VA OS: Dcc20/20
IOP: TP: OD:19 OS:10
|
|

Chronic Myelogenous Leukemia and Diabetic Macular Edema74 views71 year old female with 3 months of vision loss and not feeling well. She has been bruising on her legs. Her vision was 20/100 in each eye with macular edema. She was treated with Avastin and her CBC was checked. She had a WBC of 267 thousand and was diagnosed with CML.
|
|

wet AMD with classic extrafoveal macular neovascularization in the good eye74 views89 year old man with longstanding vision loss in the left eye presented with one month of mild vision loss in the right eye. Vision was 20/32. This eye responded to vabysmo therapy.
|
|

Wet AMD - Type 1 CNVM - RAP lesion74 views92 year old man with vision loss and very high PED. Because of worry about a PED tear, patient was treated with avastin, then lucentis, then eyelea, then vabysmo (progressively stronger meds)
|
|

32 year old female with normal vision and CHRPE74 views
|
|

West Nile Virus Multifocal Choroiditis with later CNVM74 views77 year old female with vision loss in the left eye treated with Anti-VEGF
|
|

West Nile Virus Multifocal Choroiditis with later CNVM74 views77 year old female with vision loss in the left eye treated with Anti-VEGF
|
|

West Nile Virus Multifocal Choroiditis with later CNVM74 views77 year old female with vision loss in the left eye treated with Anti-VEGF
|
|

Birdshot Chorioretinitis - Chronic Untreated with Drusen Like Material in Macula74 views72 year old female with vision changes for years just now diagnosed with Birdshot.
|
|

Idiopathic Polypoidal Choroidal Vasculopathy74 views83 year old man with wet AMD for 12 years resistant to Anti-VEGF therapy but responsive to PDT
|
|

Acute retinal necrosis74 views67 year old female Hazy vision in the right eye for 5 days.
Medical Hx: TYPE 2 DIAB.. Hypercholesterolemia.
Surgical Hx: COLECTOMY.
Systemic Meds: CRESTOR 10 MG QD. METFORMIN 500 MG QD. PROLIA Q 6 MOS. SULFA 800 MG/ TRIMETHOPRIM 160 MG TID. VALCYCLOVIR 1 GM TID. PROBIOTIC QD. CENTRUM 50+ QD. ALLERGY MED QD
VA 20/40, 20/20
IOP 19, 12
SLE: Trace AC cell OD and moderate vitreous cell OD
|
|

Paclitaxel induced cystoid macular edema - reversed when chemo stopped74 views74 year old retired physician About 2-3 weeks ago there was gradual vision loss in the right eye. The patient was seen by an ophthalmologist who saw macular swelling and injected vabysmo. He has been on chemotherapy (Carbiplatin and Carboxytaxol for 2 cancers - advanced prostrate diagnosed 2019 - has had brain surgery AND squamous lung cancers treated with radiation)
Medical Hx: Prostate cancer (Onset: 2018). Pulmonary and bone cancer metastatic. Brain cancer metastasized from prostate cancer.
Surgical Hx: Right frontal & Frontoparietal Craniotomy (Onset: 2024). Appendectomy. Hemorrhoidectomy. Herniorrhaphy. Prostate. Systemic Meds: Chemotherapy. Radiation. Eligard Every 3 Months 22.5 MG per 0.375 ML Prefilled Syringe. MIRALAX prn. Tums Freshers 500 MG Chewable Tablet. Vitamin D. XGEVA.
VA OD: Dcc20/125+1
VA OS: Dcc20/125-2
TP: OD:12 OS:15
|
|

NPDR and Severe macular ischemia sudden vision loss74 views60 year old female with sudden vision loss OD 1 week ago. VA 20/63, 20/200. OCT-A and FA shows severe macular ischemia OU
|
|

Stargardt - Mother with Stargadts and father with RP73 viewsHer mom is genetically visually impaired with Stargardts. Her father has RP. The mother was genetically tested in Boston about 23 years ago. That was when the gene was first being isolated. (The mother has seven brothers and sisters and four have stargardts and they are legally blind. Also one cousin has it.)
VA OD: 20/160 OS: 20/160
She tested positive for ABCA4
|
|

32 year old female with normal vision and CHRPE73 views
|
|

Myelinated Nerve Fiber Layer - Peripheral73 views43 year old man with floaters
|
|
| 17965 files on 180 page(s) |
 |
 |
 |
 |
 |
174 |  |
 |
 |
 |
|